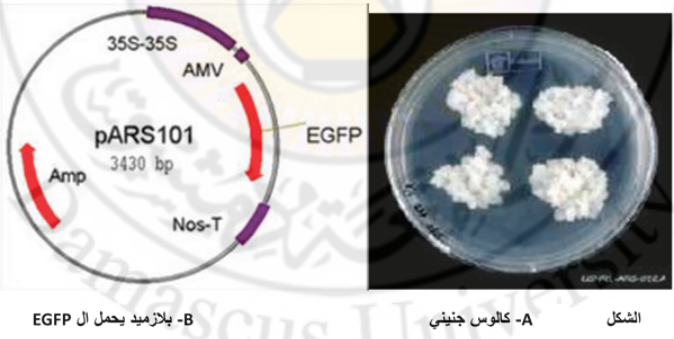

التعديل الوراثي في النبات
يستفيد الإنسان ويتعلم من الطبيعة تطوير آليات محددة في كافة مجالات علوم الحياة، وقد لاحظ العلماء إصابة النباتات بالطبيعة بمرض التدرن السرطاني الذي يصيب الشتول أيضاً في المشتل، استطاع الباحثون تحديد المسبب وأعراض المرض وآلية انتقال الاصابة، يعد مرض التدرن التاجي أحد الأمراض البكتيرية التي تسبب ظهور تدرنات سرطانية في ساق ومنطقة تاج الغراس، وتمت دراسة البكتريا المسببة للمرض وهي نوع من بكتريا التربة السالبة وتدعى الأغروباكتريوم تومافيسينس Agrobacterium tumaficiens. تحوي هذه البكتريا بلاسميد يحمل مورثات اصطناع الهرمونات النباتية، تهاجم البكتريا الخلايا والأنسجة النباتية المعرضة للجروح ويدخل إلى داخل الأنسجة وينتقل البلاسميد من البكتريا ويتحد مع جينوم الخلايا النباتية ويسخرها لإنتاج الهرمونات النباتية بشكل زائد مما يؤدي إلى تسريع الانقسام الخلوي وتنشيطه مما يشكل تدرنات أو أورام سرطانية في النبات بفعل الإصابة. وهذا نوع من التعديل الوراثي الطبيعي.
أخذ العلماء بهذه الأفكار من الطبيعة ثم قاموا بتطويرها لنقل مورثات أخرى يمكن إضافتها إلى بلاسميد الأغروباكتريوم وأصبحت هذه التقانة إحدى الطرائق الأساسية في التحوير الوراثي ونقل المورثات والحصول على نباتات معدلة وراثياً.
تعريف التعديل الوراثي:
وهو عبارة عن نقل مورثة أو أكثر من نبات أو كائن حي إلى نبات أو كائن حي آخر بإحدى طرائق الهندسة الوراثية حتى يتم الحصول على نباتات محورة وراثياً، تحمل صفات جديدة ناتجة عن التعبير الجيني للمورثات الجديدة التي نقلت إلى النبات.
أهداف التعديل الوراثي:
يهدف التعديل الوراثي في النبات بشكل عام إلى تحسين النبات، وزيادة مقاومته للأمراض والحشرات والإجهادات اللاحيوية وتحسين نوعية المنتج.
ويمكن إيجاد الأهداف بما يلي:
آ- الحصول على نباتات معدلة وراثياً تحمل صفة المقاومة للأمراض والحشرات.
ب- الحصول على نباتات تحمل صفات جديدة تعطي النبات صفات تحمل للإجهادات اللاحيوية مثل الجفاف الصقيع درجات الحرارة العالية، الملوحة ... إلخ.
ج- الحصول على نباتات معدلة وراثياً تحمل صفات مقاومة الأمراض الفيروسية.
د- يفيد التعديل الوراثي في التحسين الوراثي للنباتات من الناحية الكمية والنوعية مثل زيادة صفة الإنتاجية، تحسين نوعية المنتج مثل زيادة القدرة التخزينية، تحسين طعم الثمار، زيادة محتواها من العناصر المغذية والفيتامينات ...إلخ.
هـ- زيادة إنتاجية المواد الفعالة في النباتات الطبية والعطرية.
و- تحسين نوعية الزيت وكميته في النباتات الزيتية مثل الزيتون يمكن أن يكون أحد أهداف التعديل الوراثي زيادة نسبة الزيت في الثمار، وزيادة نوعية الزيت المنتج. كما يمكن أن يكون الهدف الحصول على نباتات مقاومة لبعض الأمراض مثل مرض التدهور السريع البكتيري في الزيتون Quick decline الذي تسببه بكتريا Xyllela fastidiosa (لا يوجد دراسات لحد الآن في هذا المجال).
ز- الحصول على نباتات متحملة لنقص العناصر المعدنية مثل نقص الحديد أو الزنك.
ل- الحصول على نباتات معدلة وراثياً تحمل صفة الإلقاح الذاتي (الخصوبة الذاتية).
ح- الحصول على نباتات معدلة وراثياً تحمل صفة إنتاج الأصبغة الأنتوسيانية، أو إنتاج بعض البروتينات النوعية الخاصة.
ط- الحصول على نباتات معدلة وراثياً تحمل صفة إنتاج الكاروتينات، مثال على ذلك الرز الذهبي.
وفي الختام لا بد من القول بأن أهداف التعديل الوراثي كثيرة ومتشعبة جداً، وتختلف بشكل كبير من نوع نباتي إلى نوع نباتي آخر حسب الهدف من زراعة النبات، مثال في نباتات الزينة، يتم الاهتمام بزيادة المحصول الزهري، وكبر حجم الأزهار، وتحسين نوعية الأزهار من حيث اللون والشكل والرائحة وفترة الإزهار وعدد مرات الإزهار في السنة، وفترة بقاء الزهرة وزيادة قدرتها التخزينية ......إلخ.
أنواع المحاصيل المعدلة وراثياً:
تقسم المحاصيل المعدلة وراثياً إلى ثلاثة أقسام:
آ- المحاصيل التي يتم إدخال صفات جديدة عليها، مثل المقاومة للمبيدات العشبية، ومقاومة أفضل للحشرات والأمراض بأنواعها المختلفة (الفطرية، البكتيرية والفيروسية)، وتحمل صفات المقاومة للإجهادات اللاحيوية (جفاف، ملوحة، صقيع...إلخ).
ب- المحاصيل التي تتم إضافة قيمة غذائية إضافية عليها مثل زيارة القيمة الغذائية للمحاصيل المستخدمة في تغذية الحيوان مثل زيادة نسبة البروتين، نسبة الفيتامينات .... إلخ.
ج- المحاصيل المستخدمة في الناحية الطبية والدوائية، مثل زيادة نسبة المادة الفعالة أو إنتاج محاصيل تحوي فائدة دوائية (2006 Fernandez and Taswell).
ومن أهم الأمثلة للمنتجات الزراعية المعدلة وراثياً:
- إنتاج صنف من البطاطا ذو نسبة عالية من النشاء.
- إنتاج أصناف من القطن مقاومة للحشرات ومبيدات الأعشاب.
- إنتاج أصناف من الذرة لها القدرة على مقاومة الحشرات، ومنها القادر على النمو في بيئات فقيرة وجافة.
- انتاج زيوت امنة الصحة مستخلصة من فول الصويا والكانيولا.
- إنتاج صنف من الأرز الغنى بالحديد وفيتامين A.
- إنتاج صنف من الذرة يحتوي على نسبة عالية من حمض الأوليك وهو من الأحماض الدهنية المفيدة أحادية غير المشبعة.
مزايا النباتات المعدلة وراثياً:
تعد تقانات التعديل الوراثي من التقانات المهمة التي تؤثر في تحسين إنتاجية المحاصيل الزراعية الطبية والغذائية من الناحية الكمية والنوعية.
ويمكن إيجاز مزايا النباتات المعدلة وراثياً بالآتي:
1- زيادة مردود المحاصيل الزراعية.
2- خفض التكاليف الزراعية، عن طريق التخفيف من استعمال المبيدات الحشرية والفطرية ومبيدات الأعشاب مع المحافظة بشكل أفضل على البيئة.
3- زيادة أرباح المزارعين.
4- الحصول على محاصيل أكثر تحملاً للظروف البيئية، وبالتالي تسمح بزراعة هذه المحاصيل المعدلة في مناطق جديدة، مما يزيد من المساحة القابلة للزراعة وزيادة العائد الاقتصادي.
5- تحسين الظروف الصحية والبيئية والقدرة على التحكم في ظروف الإنتاج.
6- إطالة فترة حفظ المنتج الزراعي وحفظ الأغذية بحالة جيدة.
7- رفع القيمة الغذائية للطعام.
8- الحصول على منتجات ذات نوعية جديدة، بسبب التحوير الوراثي.
9- إمكانية استخدام بعض المحاصيل المعدلة وراثياً كدواء لعلاج بعض الأمراض التي تصيب الإنسان.
10- زيادة إمكانية شحن المحاصيل الزراعية إلى أماكن بعيدة مع تخفيض نسبة التالف منها، بسبب تحسين نوعيتها وزيادة قدرتها على التخزين.
سلبيات النباتات المعدلة وراثياً ومخاطرها:
لاحظنا وجود فوائد كثيرة للتعديل الوراثي في زيادة الإنتاجية، وتحسين نوعية الأغذية والمحاصيل بالمقارنة مع هذه الفوائد الكثيرة التي ذكرت سابقاً لاحظ العديد من الباحثين تأثر صحة الإنسان والبيئة والتنوع الحيوي النباتي بخلل ومخاوف من النباتات المعدلة وراثياً التي يمكن إيجازها بالآتي:
1- من الممكن أن تسبب بعض النباتات المعدلة وراثياً بعض المشاكل الصحية للإنسان مثل التحسس أو بعض الاضطرابات العصبية لدى بعض الأشخاص.
2- من الممكن للنباتات المعدلة وراثياً أن تحدث خللاً في البيئة نتيجة انتقال المورثات الجديدة إلى الكائنات الحية الموجودة في الطبيعة، مثل:
آ- نقل مورثة مقاومة الأعشاب إلى المحاصيل تزيد في مقاومتها للأعشاب، ولا تحتاج إلى استخدام مبيدات الأعشاب، لكن انتقال المناعة إلى الأعشاب نفسها يجعل من الصعب مكافحتها وتصبح لا تتأثر بالمبيدات العشبية.
ب- نقل مورثات مقاومة الأمراض والحشرات إلى النباتات مثل الذرة والبطاطا والقطن أتاح للنباتات المعدلة وراثياً من إنتاج مادة سامة تقاوم الحشرات الضارة، وبالتالي تكتسب مناعة ضد الحشرات، ويمكن أن تنتقل المناعة إلى الحشرات نفسها.
ج- إمكانية حدوث تلقيح بين النباتات المعدلة وراثياً مع النباتات البرية، مما يؤدي إلى انتقال المورثات الجديدة إلى الحياة البرية، وقد يحدث خللاً في التنوع الحيوي النباتي ويحدث تلوثاً وراثياً.
د- تحدث خللا في التوازن البيئي بسبب التهجين مع النباتات البرية، مما يؤدي إلى نشوء أنواع جديدة من النباتات مما يحدث خلل في التوازن الطبيعي وتلوث الطبيعة البرية.
3- من مخاطر النباتات المعدلة وراثياً أنها يمكن أن تستخدم كسلاح اقتصادي ضد شعوب العالم الثالث عن طريق احتكارها من الشركات العالمية للبلدان المتطورة مثل شركات إنتاج البذار أو شركات التقانة الحيوية التي تنتج المواد الضرورية اللازمة للتعديل الوراثي، أو الشركات التي تهتم بالبنوك الوراثية للجينات، أو الشركات المنتجة للمواد الفعالة والبروتينات والأنزيمات هذه الشركات يمكن أن تقوم باستخدام التقانة كسلاح ضد الدول تبيع لبعض الدول، وتحرم دول أخرى وذلك حسب مصالحها الاستراتيجية.
4- يمكن أن يحدث خلل في النباتات المعدلة وراثياً من حيث نموها وتطورها أو خلل في إنتاج البروتينات النباتية المتعددة، مما يؤدي إلى حدوث اضطرابات فزيولوجية في النباتات المعدلة وراثيا.
5- من الممكن أن تظهر أمراض جديدة وحشرات جديدة، وأعشاب جديدة بسبب تلوث البيئة بمورثات جديدة لم تكن قبل موجودة.
6- لابد من أخذ الحيطة والحذر وخاصة بالنسبة للأغذية المعدلة وراثياً، لأنه لا يعرف مدى تأثيرها التراكمي على صحة الإنسان والحيوان، ولهذا لابد من دراسة آثارها الجانبية لفترة زمنية طويلة قبل السماح بإنتاجها تجارياً على المدى الواسع.
وهنا لابد أن نتكلم قليلاً عن الأمان الحيوي للنباتات المعدلة وراثياً بعد أن تعرفنا على منافعها ومضارها:
تعريف الأمان الحيوي:
مصطلح يستخدم للإشارة إلى السياسات والإجراءات المعتمدة لضمان الاستخدام الآمن لتطبيقات التقانة الحيوية المعاصرة، ومنع أو الإقلال من المخاطر المحتملة والمترتبة عن التقانات الحيوية ومنتجاتها وذلك عن طريق المراقبة المخبرية في إنتاج النباتات المعدلة وراثياً، والتحقق من عدم وجود آثار جانبية لها على سلامة الإنسان والبيئة مع التطبيق الصارم لقوانين السلامة الأحيائية.
بروتوكول قرطاجنة: (حول السلامة الأحيائية التابع للاتفاقية الدولية المتعلقة بالتنوع البيولوجي): وهذا البروتوكول هو اتفاقية بيئية دولية تهدف إلى حماية التنوع الحيوي، من الأخطار المحتملة من الكائنات الحية المحورة وراثياً والناتجة عن التقانات الحيوية المختلفة، يركز البروتوكول على وضع القواعد والشروط والقوانين والوسائل الإعلامية المتقدمة والتي تسمح بنقل الكائنات المحوة وراثياً بين الدول مع المحافظة على استدامة التنوع الحيوي وحفظه، كما يؤسس البروتوكول غرفة لتبادل معلومات السلامة الحيوية من أجل تسهيل تبادل المعلومات والخبرات حول الكائنات الحية المحورة ولمساعدة الدول في تنفيذ البروتوكول (برنامج الأمم المتحدة للبيئة، 2006).
كيف يتم الحصول على نباتات معدلة وراثياً:
يتم الحصول على نباتات معدلة وراثياً وفق الخطوات الآتية:
1- دراسة المصادر الوراثية وتحديد المورثات المهمة: تعد الدراسات الوراثية من أهم النقاط الأساسية في برنامج التعديل الوراثي. لا يمكن العمل في مجال التحوير الوراثي بدون معرفة مسبقاً بالمورثات التي سيتم نقلها من كائن حي إلى النبات أو من نبات إلى نبات، لذلك يتم أولاً:
- تحديد المورثات المهمة في برنامج التحسين الوراثي للنوع المدروس.
- تحديد مورثات المقاومة مثل مورثة Vf المقاومة لجرب التفاح.
- رسم خرائط، وراثية، وتحليل الموقع الوراثي للجينات.
- تحديد تركيب المورثة وتحديد التسلسل النيكليوتيدي للمورثات.
- تحديد الواسمات الجزيئية للمورثات المهمة.
- عمل قواعد وبيانات وراثية.
- عمل بنك وراثي للجينات، ويمكن الاستفادة مباشرة من مورثات محددة موجودة في البنك الوراثي يمكن طلبها واستخدامها مباشرة في التعديل الوراثي.
حالياً في أغلب بلدان العالم يتم الحصول على المورثات المطلوبة مباشرة من البنوك الوراثية العالمية المنتشرة في الدول المتقدمة، حيث يتم شراءها وجاهزة للتطبيق المباشر دون الحاجة إلى البحث وتنفيذ الدراسات التي ذكرت في الأعلى.
2- نقل المورثة أو المورثات إلى النباتات المراد تحويره:
يتم نقل المورثات المرغوبة إلى الأجزاء النباتية لغرض التعديل الوراثي بوساطة عدة تقانات من الهندسة الوراثية وهي:
2-1- زراعة البروتوبلاست:
تعد تقانة عزل البروتوبلاست وزرعها إحدى تقانات الهندسة الوراثية بحيث تسمح كونها خالية من الجدار البكتوسللوزي الخلوي من إدخال المورثات والبلاسميدات، أو أجزاء من الـ DNA أو الـ RNA أو الفيروسات التي تحمل المورثات المطلوبة، إذ يتم انتقالها إلى داخل البروتوبلاست وتندمج مع جينوم الخلايا النباتية ويتم الحصول على بروتوبلاست معدلة وراثياً. ولابد من تطورها وتجديدها للحصول على نباتات كاملة معدلة وراثياً كما هو موضح بالشكل (1).

شكل (1) التعديل الوراثي بالبكتريا Agrobacterium tumefaciens بالفرد الحيوي
تتوقف فعالية التعديل الوراثي في البروتوبلاست على مجموعة من العوامل الأساسية وهي:
أ- تقانة التعديل الوراثي المتبعة، تركيز البروتوبلاست، وتركيز البلاسميدات، أو الـ DNA الحاملة للمورثة المراد إدخالها مصدر، البروتوبلاست، المعاملات الأولية المختلفة، النوع النباتي، مكونات الوسط المغذي....إلخ.
ب- تقانة الكشف عن البروتوبلاست المعدلة وراثياً بإحدى تقانات الكشف التي سيتم تفصيلها لاحقاً.
ت- قدرة الخلايا البروتوبلاست المحورة على التجديد وتكوين نباتات كاملة وهنا لابد من دراسة كثير من العوامل التي تؤثر في التجديد والتكوين المباشر للنباتات أو غير المباشر، كزراعة البروتوبلاست أو إنتاج نباتات متباينة وراثياً.
2-2- التعديل الوراثي بوساطة الأغروباكتريوم:
تعد تقانة التعديل الوراثي بالبكتريا طريقة غير مباشرة من تقانات الهندسة الوراثية المطبقة في الحصول على نباتات محورة وراثياً. يتم تحميل المورثات المراد نقلها على البلاسميد الذي يحمل بدوره على بلاسميد البكتريا A.t، عند دمج الأغروباكتريوم Agrobacterium tumefaciens مع الأجزاء النباتية تهاجم البكتريا الخلايا النباتية وينتقل البلاسميد T. DNA الحامل للمورثة الجديدة وتندمج مع جينوم الخلايا النباتية ويتم الحصول على خلايا معدلة وراثياً والتي تتطور وتعطينا نباتات معدلة وراثياً كما هو موضح في الشكل (1).
- مثال عن التعديل الوراثي بالأغروباكتريوم في التفاح:
تم استخدام أجزاء ورقية لنموات خضرية مكاثرة بالأنسجة استعملت سلالة EHA1015 من البكتريا Agrobacterium tumefaciens التي تحمل مورثة g2PS1 التي تعطي صفة المقاومة للأمراض الفطرية، حملت المورثة على بلاسميد (PGreen II 355-g21) الذي أدخل إلى سلالة البكتريا المستعملة (EHA1015) وزرعت البكتريا بشكل مشترك مع الأوراق النباتية مما أدى إلى انتقال المورثة إلى الخلايا النباتية وتم الحصول على أجزاء ورقية معدلة وراثياً. وقد تم الكشف عن الأجزاء النباتية المعدلة وراثياً باستخدام مورثة bar المحملة على البلاسميد، تعطي هذه المورثة أنزيم فوسفوتيريسين PPT الذي يبطل مفعول المبيد العشبي Basta مما يبطل التأثير السام للمبيد العشبي على الأجزاء المعدلة وراثياً وتبقى على قيد الحياة. بينما الأنسجة غير المعدلة تموت بسبب التأثير السام للمبيد العشبي.
وتم التعديل الوراثي باتباع الخطوات الآتية:
1- تم إكثار التفاح بزراعة النسج في وسط مغذ MS والمضاف له BAP 1ملغ/ل، وأعيدت عملية الإكثار مرة كل 4 أسابيع ضمن شروط معقمة.
2- أخذت الأوراق المتكونة على النموات الخضرية للتفاح صنف كولدن من طور الإكثار، وقطعت إلى قطع صغيرة وجرحت بالشفرة.
3- لقحت مع البكتريا Agr T. الذي يحمل البلاسميد لمدة 1/2 ساعة.
4- نقلت وزرعت الأوراق بشكل مشترك مع المعلق البكتيري الذي يحمل المورثة g2ps1 التي تعطي صفة المقاومة للأمراض الفطرية لمدة يومين أو ثلاثة.
5- نقلت الأجزاء الورقية إلى وسط يحوي مضاد حيوي للتخلص من البكتريا. هنا أضيف مزيج من المضادات الحيوية 150 مغ من الـTecaricillin + 250 مع/ل من الـ Cefotaxime للتخلص من البكتريا.
6- تنقل الأجزاء الورقية إلى أوساط تجديد وانتخاب تحوي PPPT+ TDD+MS 3 مع/ل (كعامل انتخاب).
ووضعت العينات بالظلام لمدة ثلاثة أسابيع بدرجة 25 م ثم بعدها تنقل إلى الإضاءة لتكوين نموات خضرية، وهنا لابد من الإشارة إلى أن العينات النباتية المحورة تبقى على قيد الحياة، في حين تموت العينات غير المحورة بفعل التأثير السام للمبيد العشبي بسبب عدم احتوائها على PPT. كما يتم التأكد من العينات الحية المحورة وراثياً بالكشف الجزيئي بالـ PCR.
7- يتم إكثار النموات الخضرية المعدلة وراثياً كمرحلة أولى، ثم تنقل إلى وسط مغذ مناسب للتجذير للحصول على نباتات كاملة معدلة وراثياً.
8- يتم التحقق من الثبات الوراثي للنباتات ومدى مقاومتها لجرب التفاح.
2-3- قذف المورثات المباشر بالمدفع الجيني Biolistic Gun Method:
يتم إدخال المورثات إلى الخلايا النباتية مباشرة. ففي هذه الطريقة يتم ربط المورثات أو الـ DNA إلى جسيمات صغيرة جداً من الذهب أو جزيئات التنجستين والتي يتم إطلاقها أو قذفها تحت الضغط العالي إلى داخل خلايا الأنسجة النباتية، تخترق الجسيمات الحاملة للمورثات جدار والغشاء الخلوي، ثم تنفصل المورثات عن جسيمات الذهب وتندمج مع جينوم الخلايا داخل النواة (الشكل 2).
تم تطبيق هذه التقانة في العديد من المحاصيل الزراعية وخاصة نباتات وحيدة الفلقة كالقمح والذرة. تستخدم تقانة المدفع الجيني في نباتات وحيدة الفلقة لأن استخدام البكتريا في التعديل الوراثي ينجح بشكل كبير في نباتات ثنائية الفلقة، ونسبة نجاحه في النباتات وحيدة الفلقة قليلة، لهذا يتم التركيز على استخدام المدفع الجيني.

شكل (2) التعديل الوراثي باستخدام المدفع الجيني
2-4- الحقن الدقيق المباشر بواسطة إبر دقيقة جداً:
يتم إدخال المورثات مباشرة إلى داخل الخلايا النباتية بواسطة إبر دقيقة جداً 0.1-0.5 ميكرون. ويتم الحصول على النباتات المعدلة وراثياً بعد اندماج المورثات المحقونة مع جينوم الخلايا وبدء انقسامها.
يتم التحقق من الخلايا المعدلة وراثياً بإحدى اختبارات الجينات الكاشفة، ويتم تجديد الأنسجة المعدلة وراثياً للحصول على نباتات محورة كاملة.
5-2-7-13-إدخال المورثات بالصدمة الكهربائية Electroporation Method
يتم عمل صدمة كهربائية للخلايا النباتية أو البروتوبلاست مما يؤدي إلى فتح ثغرات مؤقتة في الغشاء السيتوبلاسمي مما يسهل دخول المورثات أو الـ DNA أو البلاسميد إلى داخل الخلايا أو البروتوبلاست واندماجها مع جينوم الخلايا ويحصل التعديل أو التحوير
الوراثي.
2- 6- الطريقة الكيميائية بالبولي إيتيلين غليكول PEG Method:
يعمل مركب البولي إيتيلين غليكول على تجميع المورثات أو الـ DNA أو البلاسميدات الحاملة للمورثات على سطح الخلايا النباتية أو أسطح خلايا البروتوبلاست مما يساعد في اندماجها مع بعضها البعض مما يؤدي إلى دخول المورثات أو البلاسميد إلى داخل الخلايا النباتية، ويحدث الاندماج ويتم الحصول على خلايا معدلة وراثياً وعند تجديدها يتم الحصول على نباتات محورة وراثياً. ولابد من التذكير بأن هذا المركب PEG تم استخدامه مسبقاً في دمج البروتوبلاست.
2-7- تطبيق الطريقة الكيميائية مع الصدمة الكهربائية بشكل مشترك:
استخدمت هذه الطريقة بنجاح في عدة محاصيل زراعية فقد أضيف مركب الـ PEG إحداث صدمة كهربائية، حيث يعمل الـ PEG على تجميع المورثات على أسطح البروتوبلاست، والصدمة الكهربائية تحدث فتحات في الغشاء السيتوبلاسمي مما أدى إلى زيادة مسامية الأغشية الخلوية في البروتوبلاست مما سهل دخول المورثات أو البلاسميد إلى داخل الخلايا النباتية واندماجها مع جينوم الخلية والحصول على خلايا أو بروتوبلاست معدلة وراثياً. وإذا تطورت وتجددت وأعطت نباتات كاملة تكون محورة وراثياً، يمكن الكشف عنها وتقييمها بالبيوت الزجاجية. وقد تم استخدام هذه التقانة في بروتوبلاست نبات الرز، وقد تم الحصول على نباتات كاملة محورة وراثياً.
2-8- التعديل باستخدام جسيمات ليبيدية حاملة للبلاسميد Lipofection Method:
يتم تحميل البلاسميدات على جسيمات الليزوزوم، وهي جسيمات ليبيدية، يتم دمج الجسيمات الليبيدية الحاملة للبلاسميد مع الخلايا النباتية أو البروتوبلاست، وتخترق الجسيمات الغشاء الخلوي عن طريق اندماجها مع الغشاء الخلوي ويتم تحرير البلاسميدات داخل الخلية وتندمج مع جينوم الخلايا ويحدث التعديل الوراثي.
2-9- التعديل الوراثي باستخدام الأمواج فوق الصوتية Ultrasound Method:
تعمل الأمواج فوق الصوتية عند معالجة الخلايا النباتية على زيادة مطاطية الجدر الخلوية مما يزيد من فرص دخول البلاسميدات إلى داخل الخلايا.
ولابد من الذكر أخيراً حول نسبة استخدام تقانات التعديل الوراثي عالمياً. تعد تقانة البكتريا غير المباشرة أكثر التقانات استخداماً إذ تصل نسبتها إلى 64% من نسب التعديل الوراثي المنفذة عالمياً، تليها تقانة المدفع الجيني بنسبة 21 % ويوضح الشكل (3) نسب استخدام التقانات المختلفة في التعديل الوراثي المطبقة على مستوى العالم.

شكل (3) نسب الأعمال الخاصة بالتعديل الوراثي
3- طرائق الكشف عن التعديل الوراثي:
بعد نقل المورثات إلى النبات بإحدى طرائق الهندسة الوراثية، لابد من التمييز بين الأنسجة النباتية المحورة وراثياً من الأنسجة والخلايا غير المحورة، ويتم ذلك على مستوى الخلايا النباتية أو البروتوبلاست أو الكالوس أو الأنسجة الورقية. يتم الكشف بعد أسبوعين من التعديل الوراثي بإحدى التقانات الآتية:
1- تزويد البلاسميد المدخل إلى الخلايا النباتية بمورثة مقاومة لبعض المضادات الحيوية مثل الكنامايسين والهيغرومايسين كمورثات، انتخاب ففي هذه الحالة تنقل الخلايا أو الأنسجة النباتية إلى وسط يحوي الكنامايسين مثلا، 25-100مغ/ل لفترة من الزمن فالخلايا المحورة تحمل صفة المقاومة تبقى على قيد الحياة بينما الخلايا غير المحورة تموت لأنها لا تحمل الجين المقاوم للمضاد الحيوي.
2- تزويد البلاسميد المدخل بمورثة مقاومة لمبيد عشبي الـ PPT، وقد تم شرح آلية عملها في الانتخاب في مثال التحوير الوراثي بالأغروباكتريوم في التفاح مسبقاً.
3- تزويد البلاسميد المدخل إلى الخلايا بمورثة مولدة للبروتين (Green (GFP Fluorescent Protein. ويتم الكشف عن مدى وجود البروتين عن طريق تعريض الخلايا أو الأنسجة المحورة إلى الأشعة وتتلون الخلايا النباتية المحورة باللون الأخضر في حين تبقى الأنسجة غير المحورة بيضاء اللون كما هو موضح بالشكل التالي.
4- تزويد البلاسميد المدخل بمورثة Gus التي تعمل على تنشيط أنزيم glicuronidase ẞ. وهذا الأنزيم يمكن الكشف عنه باختبار Gus-assay أو تشريحياً أو بطرائق البيولوجيا الجزيئية.
5- تزويد البلاسميد المدخل ببعض المورثات الأخرى المستخدمة في الكشف الإيجابي عن الخلايا المحورة وراثياً مثل مورثة (Pmi) فوسفومانوز إيزوميراز Phosphomanase Isomerase . أو مورثات أخرى تستطيع بطرائق مختلفة التمييز بين الخلايا المحورة وراثياً عن الخلايا غير المعدلة.
يطلق على الطرائق التي تقضي بموت الخلايا غير المحورة بالطرائق السلبية، كما يطلق على الطرائق التي تحافظ على حياة الخلايا بالطرائق الإيجابية.
4- تجديد الأنسجة النباتية المحورة Regeneration system:
لا يمكن القول بأنه تم الحصول على نجاح كامل في التعديل الوراثي دون وضع تقانة تجديد بهدف الحصول على نباتات كاملة معدلة وراثياً بدءاً من الخلايا النباتية المعدلة، وهذا ما نطلق عليه نظام التجديد Regeneration system.
توجد أربع طرق لتطوير التجديد كما هو موضح بالشكل (4):

شكل (4): أشكال التجديد
5- تقييم النباتات المعدلة وراثياً:
تنقل النباتات المعدلة وراثياً بعد تجديدها داخل الأنابيب إلى بيت زجاجي محكم العزل بهدف تقييمها ومعرفة مدى تحملها للصفة المرغوبة وماهي درجة التحمل؟ هل توجد تباينات وراثية مع النبات الأم؟ وهل حافظت النباتات المعدلة وراثياً على صفات الأم+ الصفة الجديدة الناتجة عن نقل المورثة ؟ هل أدت عملية النقل المورثي إلى ظهور صفات غير مرغوبة ؟ هل تشبه الثمار الناتجة عن النبات المعدل وراثياً في صفاتها ونوعيتها صفات ثمار النبات الأم غير المعدل وراثياً.
كما لابد من أخذ كافة الاحتياطات حتى لا تنطلق حبوب الطلع من النباتات المعدلة وراثياً إلى خارج البيت الزجاجي حتى لا يتم تلوث البيئة وراثياً، هنا تجدر الإشارة بتطبيق قواعد الأمان الحيوي بشكل صارم.
العوامل المؤثرة في التعديل الوراثي Factors affecting plant Transformation
يجب تحقيق هدفين أساسيين لنجاح التعديل الوراثي في النبات:
أولاً - نقل المورثات من نبات إلى آخر أي تطبيق تقانة المناسبة لنقل المورثة أو المورثات من كائن حي إلى النبات. وهذا الأمر بغاية الأهمية للحصول على خلايا أو أنسجة معدلة وراثياً. تؤثر مجموعة كبيرة من العوامل لتحقيق هذا الهدف وأهمها:
1- استخدام تقانة النقل المناسبة من تقانات الهندسة الوراثية، مثلاً بالنسبة للنباتات وحيدة الفلقة، يفضل استخدام تقانة المدفع الجيني Bioletic Method كما هو الحال في القمح والذرة. أما بالنسبة للنباتات ثنائية الفلقة يفضل استخدام تقانة النقل المورثي بالأغروباكتريوم Agrobacterium tumefaciens.
2- استخدام الأجزاء النباتية المناسبة خلايا، بروتوبلاست، كالوس، أوراق، فلقات، قمم نامية... إلخ. يختلف الجزء النباتي المناسب بحسب الأنواع النباتية. كما يؤثر عمر النبات الأم وموعد زراعة الأجزاء النباتية... إلخ.
3- استخدام سلالة الأغروباكتريوم المناسبة: لابد من اختيار السلالة المناسبة من البكتريا التي تحقق أعلى نسبة من التعديل الوراثي، كما لابد من تحديد التركيز الأنسب من البكتريا (حسب الكثافة البكتيرية OD) والفترة الزمنية للزراعة المشتركة بين الأجزاء النباتية والبكتريا.
4- الوسط المغذي ومكوناته تلعب دورا في نسبة التعديل الوراثي، مثل تركيب الوسط المغذي من الأملاح المعدنية، تركيز السكروز، طبيعة الوسط المغذي، محتوى الوسط المغذي من الهرمونات النباتية وتوازنها ونوعيتها، PH الوسط، نوع المضادات الحيوية المضافة إلى الوسط المغذي لقتل خلايا البكتريا المستخدمة في التعديل الوراثي.
5- الشروط الجوية المستخدمة في تحقيق التعديل الوراثي مثل الحرارة، الإضاءة (شدتها ونوعيتها) .... إلخ كلها تؤثر في نسبة التعديل الوراثي.
ونشير إلى عدم وجود عوامل ثابتة للأنواع النباتية المختلفة، فهناك لكل نوع نباتي عوامل محددة تؤثر في نسبة التعديل الوراثي وتختلف من نوع نباتي إلى نوع نباتي آخر.
ثانياً: وضع تقانة لتجديد النبات Regeneration System:
بعد الحصول على خلايا أو أنسجة نباتية معدلة وراثياً، والتحقق من التعديل الوراثي بإحدى تقانات الكشف التي سبق شرحها.
فلابد من وضع تقانة مناسبة للتجديد أي الحصول على نباتات كاملة بدءاً من الخلايا النباتية او الكالوس او الاوراق.
تختلف العوامل المؤثرة بتجديد النباتات وذلك حسب طريقة التجديد مباشرة أو غير مباشرة للأجزاء النباتية المختلفة وذلك حسب ما هو موضح بالشكل (4).
تختلف العوامل المؤثرة في تجديد الخزعات النباتية بحسب طريقة التجديد، مثلاً تكوين البراعم غير المباشر لابد في المرحلة الأولى من تكوين الكالوس وإكثاره، كمرحلة أولى وهذا يتطلب إضافة الأوكسين D2.4. بتراكيز تختلف من نوع نباتي إلى نوع نباتي آخر، ويعد الحصول على الكالوس العضوي ينقل إلى وسط جديد يحوي ميزان هرموني جديد بهدف تكوين براعم بدءاً من الكالوس المعدل وراثياً. ويتوجب هنا في هذه المرحلة إضافة السيتوكينين بتركيز محدد والتوازن الهرموني بين الأوكسين والسيتوكينين في هذه المرحلة يكون لصالح السيتوكينين. ويتوجب في مرحلة لاحقة إكثار البراعم المتكونة من الكالوس بهدف الحصول على مصدر مستمر من النموات الخضرية وبعد مرحلة إكثار النموات الخضرية التي تتطلب أيضاً شروط وعوامل محددة مثل التوازن بين Cyt/Aux1. كما يفضل ألا يحتوي التركيب المعدني للوسط المغذي على تراكيز عالية من نترات الأمونيوم حتى لا تصاب النموات الخضرية المتكونة بظاهرة الشفافية.

الشكل (5): التعديل الوراثي بشكل مباشر او غير مباشر في النبات
ويجب تجنب كافة العوامل التي تشجع على تكوين نموات شفافة حتى يتم الحصول على نموات جيدة النمو صالحة للنقل إلى وسط تجذير خالٍ من السيتوكينين مع إضافة الأوكسين، وعندها يتم الحصول على نباتات كاملة معدلة وراثيا جاهزة للنقل إلى البيت الزجاجي.
تختلف العوامل المؤثرة في تجديد الأنسجة النباتية المعدلة وراثياً بحسب النوع النباتي، حسب طريقة التجديد، وحسب نوعية الأجزاء النباتية المزروعة.
يم تقييم النباتات المعدلة وراثياً في البيت الزجاجي، ومتابعة التعبير المورثي للمورثات الجديد بهدف تثبيت الصفات الجديدة التي تحملها النباتات المعدلة وراثياً.
الاكثر قراءة في الزراعة النسيجية
اخر الاخبار
اخبار العتبة العباسية المقدسة